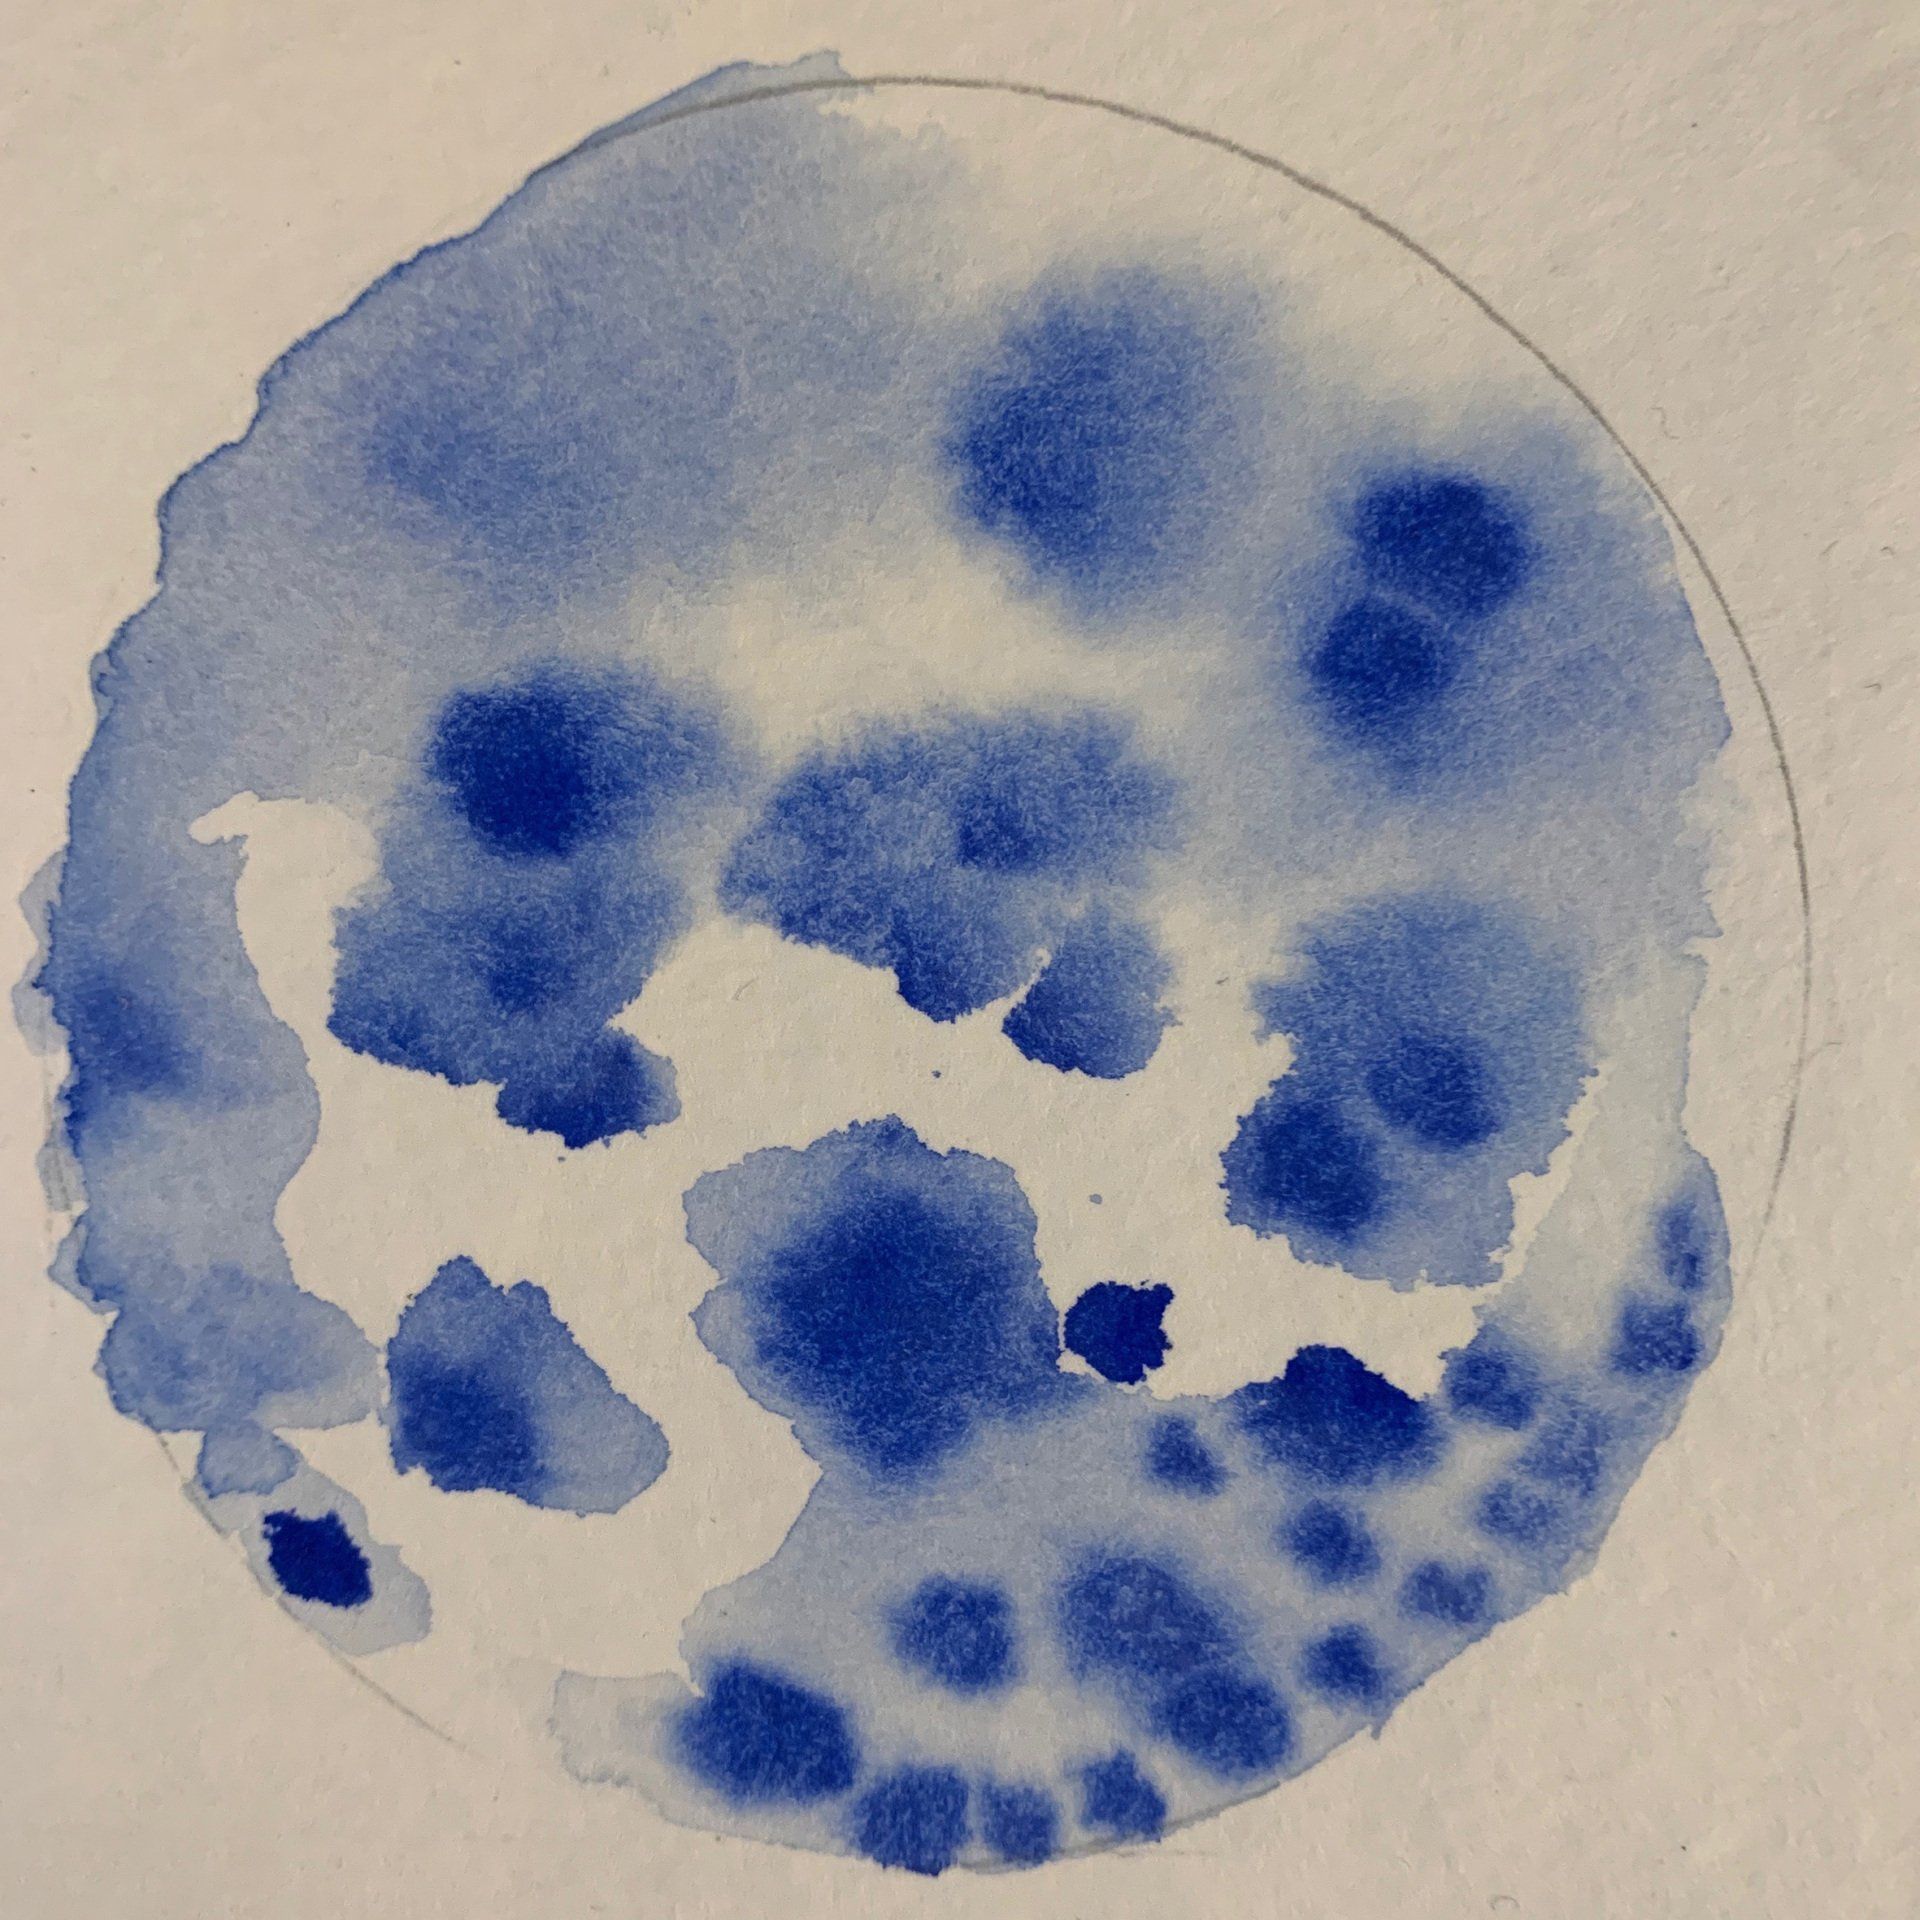

Norma Siguelboim
Nacida en Argentina 1960, estudié en la Escuela Superior de Bellas Artes, E. de la Cárcova (1986/89) Talleres particulares con C.Althaus, A.Macchi y Pájaro Gómez
Premios:
2016 Mención trienal de escultura, Víctor Roverano, Quilmes; 2015 Primer Premio Adquisición Salón Nacional en Escultura, Palais de Glace; 2014 Premio Adquisición“ Gob. de la Prov. de Santa Fe” XCI Salón de Mayo; 2013 Tercer Premio Salón Nacional Palais de Glace: 3º y Menciones (2012/2000); 2010 Primer premio Salón Nacional de La Pampa, y 3º Premio (2008) y 2º Premio (2002); 2008 Primer premio IX salón pequeño formato, Quinta Trabucco, Vicente López; 2007 Mención especial del jurado, IV concurso E. Romano, Museo Raggio; 2005 Premio adquisición, universidad del Litoral, Santa Fe. Y Mención (2000); 1999 Mención concurso Oscar Gálvez, Museo Nacional de Bellas Artes; 1998 Mención pequeño formato en la Asociación de artistas (SAAP); 1995 Segundo Premio adquisición, Manuel Belgrano, museo Sívori; 1989 Primer Premio concurso al aire libre, Escuela La Cárcova.
Seis Simposios Internacionales de escultura Monumental (2009-2013) en Italia Canadá, EEUU. Exposición individual en Praga, y exposiciones colectivas en Rep. Dominicana, Paris, Chile, Tokio. 10 años en el Jardín Larreta. Botánico. Metrovías, feria ArteBa
2018 participa en la Bienal de Arte con una instalación flotante en el Río Negro, Resistencia, Chaco.
El Abrazo (Huellas - 06/2021)
Tratando de soltar miedos……. “me entrego al Abrazo”
Al abrazo de las personas queridas que me rodean y a las que me acompañan aunque ya no estén. Al abrazo con ciertas plantas y animales, al calor del sol, de los colores y los aromas que envuelven mis sentidos, abrazando este canto del Mantra Pushpam con su vibración referente al Agua, que me hace latir el corazón más despojado, casi a flor de piel, ésta meditación me acerca a ese sentimiento.
EN ESTE CUENTO me remitiré al miedo a la muerte, la soledad, cuyos pensamiento me sigue abarcando por etapas, entonces me refugio en los Abrazos.
El abrazo de seres queridos para ir diluyendo el gran temor de ser finitos.
El tiempo pareciera correr muy rápido para vivir todo lo que me hace vibrar.
Me apuro, tropiezo y luego me detengo, sintiendo, para no perder mi esencia. “Soy como un torbellino constante de ideas, trabajo y emociones”.
Elegí transitar una búsqueda entregándome al arte todos los días. Esto me fue posibilitando el ir soltando estructuras muy arraigadas. Sorprendiéndome de adquirir cierta fortaleza ante la adversidad, y también seguir jugando con el espacio -envolvente, gracias el aprendizaje que la escultura me posibilitó entender y sentir. Entender el espacio me es fundamental.
Entonces, bajo la emoción que en este seminario con Andrea Juan y Gabriel Penedo Diego me arriesgo a incursionar en escribir un cuento, imaginándome ser un Pez….
Transcurría el año 2021, en un paseo otoñal me detuve a soñar. Relajando y soltando deseos y miedos escribí un CUENTO que fue creciendo con la emoción de un sentimiento…
El ABRAZO
Paseando a orillas del mar avisté dos aves que flotaban a la deriva, de pronto sintieron bajo sus patas una gran vibración en las aguas. Metieron sus cabezas bajo la superficie descubriendo lo que sería una fiesta a sus sentidos… un torbellino formado por pequeños peces que giraban y giraban a toda velocidad, entre-mezclando las tonalidades del agua. Testigos de ese inquietante temblor vieron un Cardumen alborotado que luchaba por romper su encierro.
Agitándose dentro de una red, cientos de peces lograron romperla y se dieron al escape por un pequeño espacio, alejándose uno por uno, en una danza sincronizada de coordinación absoluta. Contentos de seguir su ruta migratoria, desovarían en un banco a miles de futuros individuos, renovando el ciclo natural.
Uno de los peces, siempre distraído por su imaginación, dejó atrás al grupo al divisar una vistosa flor púrpura, que yacía en el fondo del mar.
Ese pez era SARDIN, conocido por su inocencia y sentido de la dispersión …Estaba tan encandilado por la belleza de esa flor encontrada, que tomándola suavemente entre sus dientes y guiándose por la luz de la superficie, pegó un gran salto fuera del agua. La brisa salada le acarició el lomo y con ese vigor, comenzó a agitar su hermosa flor a modo de ofrenda hacia la vida..
Uno de los pájaros atento al movimiento, se acercó suavemente al pez y en vez de atacarlo, lo rodeó entre sus alas en un gran “abrazo volador”. Tal demostración de afecto entre dos especies tan diferentes se convirtió en leyenda.
Al tocarlo con sus plumas, el ave le transfirió un poco de su color blanco a SARDIN cuyas escamas quedaron matizadas de plateado y blanco.
El pez blanquecino decidió seguir viaje y repetir el asombroso abrazo con otros seres. Cada uno que él rozaba con sus aletas, le permitía incorporar un tono, convirtiéndose en una llamativa especie multicolor.
SARDIN disfrutaba de su tiempo libre, animándose a enfrentar nuevos desafíos. Nadaba muchos kilómetros por día, dando volteretas, arrimándose a rincones nunca antes explorados. Avanzaba contra la corriente luchando y también se dejaba flotar ligeramente de lateral entre filosos abismos.
Así fue que también se topó con peligrosos enemigos. Atraído por su vistoso aspecto un enorme tiburón se le acercó con el ímpetu de devorarlo, la persecución duró varios minutos cuando recibió un tremendo coletazo, dejándolo inerte en el fondo del mar.
Allí permaneció quieto un buen rato lo que hizo que su amenazante bestia creyera que estaba muerto y se alejara. El pez un tanto mareado, y con bastante miedo, creyó ver las huellas de sus antepasados impresas en las rocas. Abrazándose fuertemente a la que imaginó ser la huella de su padre, pudo soltar el dolor de su pérdida y entendió la importancia de disfrutar cada día. Entonces nadaba más cerca de la superficie sintiendo el abrazo del sol, y al agitar su cola las burbujas se transformaban en una densa espuma multicolor.
Deslizándose lentamente se hizo amigo de enormes tortugas, cangrejos, mantarrayas y todo tipo de criaturas, nadando hacia zonas profundas y atravesando arrecifes. Se relacionaba aprendiendo de otros, oyendo las más disimiles historias de vida. El sonido infantil de risas que provenían de la orilla, le recordaba las travesuras de su infancia entonces se acercaba y con su panza les acariciaba los pies.
El cosquilleo que le producía tanta adrenalina, mantenía su imaginación a flote. Pasó varios años parte ocultándose, parte atreviéndose a revolcarse entre las plantas o en la arena, donde dibujaba formas con su cuerpo.
Así fue que en un mágico amanecer, sintió la vibración de un compás que se adueñaba de él latiendo a su ritmo, el sonido de un Mantra le recordaba épocas pasadas..
empezó a nadar más lento, dejándose llevar por el fluir del agua envuelto en una calma que le llenaba el alma. A lo lejos reconoció ver su Cardumen y acercándose el corazón le latía fuertemente abrazándolos con sus aletas
Una gran felicidad se apoderaba de él nuevamente para entregarse confiado al Abrazo, ese abrazo verdadero, abrazo consigo mismo y con los suyos….
Haga click sobre las imágenes para vista completa